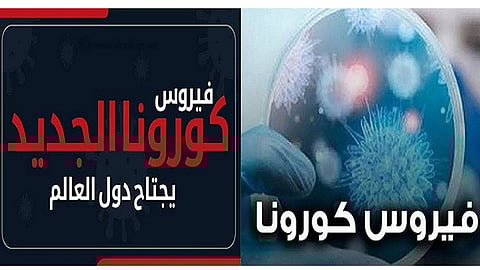

يواصل فيروس كورونا الجديد «كوفيد 19» التمدد في دول العالم، حيث أعلنت العراق، اليوم الخميس، عن تسجيل سادس حالة بالفيروس، كما أكدت كل من «إستونيا.. الدنمارك.. رومانيا.. والنرويج» تسجيل أول حالة بفيروس كورونا، بينما اعتبر رئيس الوزراء الأسترالي أنه وباء عالمي كبير يحتاج لتحرك عاجل.
العراق
أعلنت وزارة الصحة العراقية، اليوم تسجيل أول إصابة بفيروس كورونا في العاصمة بغداد، ما يرفع عدد الإصابات إلى 6 حالات، وقال بيان للوزارة: «تبين وزارة الصحة اكتشافها حالة شاب في بغداد مصاب بفيروس كورونا المستجد كان قد عاد للعراق من إيران وراجع إحدى المؤسسات الصحية في بغداد وأخذت له الفحوصات المختبرية وتم الحجر عليه».
وأضاف: «تبين في ما بعد أن نتيجة الفحوصات المختبرية موجبة وهو حاليًا بصحة جيدة في أحد المستشفيات الخاصة ببغداد، وتم اتخاذ كل الإجراءات المطلوبة لمتابعة حالته وحسب اللوائح الصحية العالمية».
إستونيا
قالت السلطات في إستونيا، إنه تم تسجيل حالة إصابة مؤكدة بفيروس كورونا.
الدنمارك
أكدت السلطات في الدنمارك تسجيل أول حالة بفيروس كورونا لشخص عائد من شمالي إيطاليا.
رومانيا
أعلنت السلطات الصحة الرومانية، الخميس، عن أول إصابة بفيروس كورونا المستجد (كوفيد-19) في البلاد، بينما سجلت النرويج تسجيل أول إصابة بالفيروس لشخص عائد من الصين.
وقال وزير الدولة بوزارة الصحة في رومانيا، هورياتو مولدوفان: "تلقينا نتائج مخبرية إيجابية لفيروس كورونا من معهد ماتي بالس في بوخارست تعود لمريض من مقاطعة غورج".
كما أعلنت وزارة الخارجية الرومانية أن مواطنًا إيطاليًّا كان متواجد على أراضيها خلال الفترة من 18 إلى 22 فبراير، تم تشخيص إصابته بفيروس كورونا لدى عودته إلى بلاده.
النرويج
من جانب آخر، أعلنت السلطات الصحية النرويجية تسجيل أول إصابة بفيروس كورونا في البلاد لشخص عاد من الصين الأسبوع الماضي، لكنها أكدت أن المريض ليس في وضع خطر.
وصرّحت المسؤولة في المعهد النرويجي للصحة العامة لاين فولد بأن "الشخص ليس مريضًا، إنه بصحة جيدة ولا تظهر عليه أي عوارض". مضيفة "نستبعد أن يكون قد نقل العدوى" لآخرين.
وأوضح المعهد أن الفحوص المخبرية الروتينية "جاءت إيجابية" وكشفت وجود آثار للفيروس المستجد.
أستراليا
من جانبه قال رئيس الوزراء الأسترالي سكوت موريسون: «نتعامل مع فيروس كورونا كوباء عالمي، وخطر حدوث وباء عالمي بسبب كورونا كبير للغاية».
وكانت سلطات أستراليا قد أعلنت رفع درجة التحذير من السفر لكل من اليابان وكوريا الجنوبية إلى المستوى الثاني، وهو ما يعني أنه يجب على جميع المسافرين توخي الحذر بدرجة عالية، وذلك بعد ارتفاع عدد الإصابات بفيروس "كورونا" في البلدين بشكل كبير على مدار الأيام الماضية.
وفي وقت سابق، أعلن مسؤولو الصحة في أستراليا ارتفاع عدد الإصابات المؤكدة بفيروس كورونا في البلاد إلى 22 حالة، عقب تسجيل حالة جديدة كان قد تم إجلاؤها من على متن سفينة «دايموند برنسيس» السياحية في اليابان مؤخرًا.
عدد وفيات كورونا
وارتفع عدد الوفيات جرّاء انتشار فيروس كورونا بالصين، اليوم الخميس إلى ألفين و746 حالة، وأفادت اللجنة الحكومية للصحة، بأن عدد الوفيات جراء الفيروس خلال الساعات الـ24 الأخيرة، بلغ 29 شخصًا.
وأشار البيان إلى أن عدد الإصابات التي تم تسجيلها خلال الفترة ذاتها وصل إلى 433 إصابة، ليرتفع بذلك العدد الإجمالي للإصابات منذ انتشار الفيروس إلى 78 ألفًا و497 إصابة.
وظهر الفيروس الغامض في الصين، لأول مرة في 12 ديسمبر 2019، بمدينة ووهان (وسط)، إلا أن بكين كشفت عنه رسميًّا منتصف يناير الماضي.
اقرأ أيضًا: